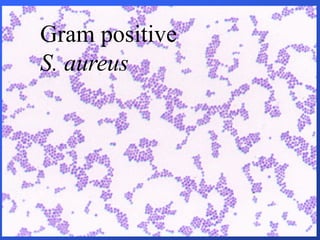
Gram positive
S. aureus

The document outlines the history and evolution of microbiology, highlighting key figures such as Robert Hooke, Antoni van Leeuwenhoek, Louis Pasteur, and Robert Koch, along with their contributions to disproving spontaneous generation and establishing germ theory. It details significant advancements such as pasteurization, the development of pure culture techniques, and the discovery of antibiotics. Additionally, the scope of microbiology spans medical, industrial, pharmaceutical, and environmental importance, covering areas from disease causation to biotechnological applications.